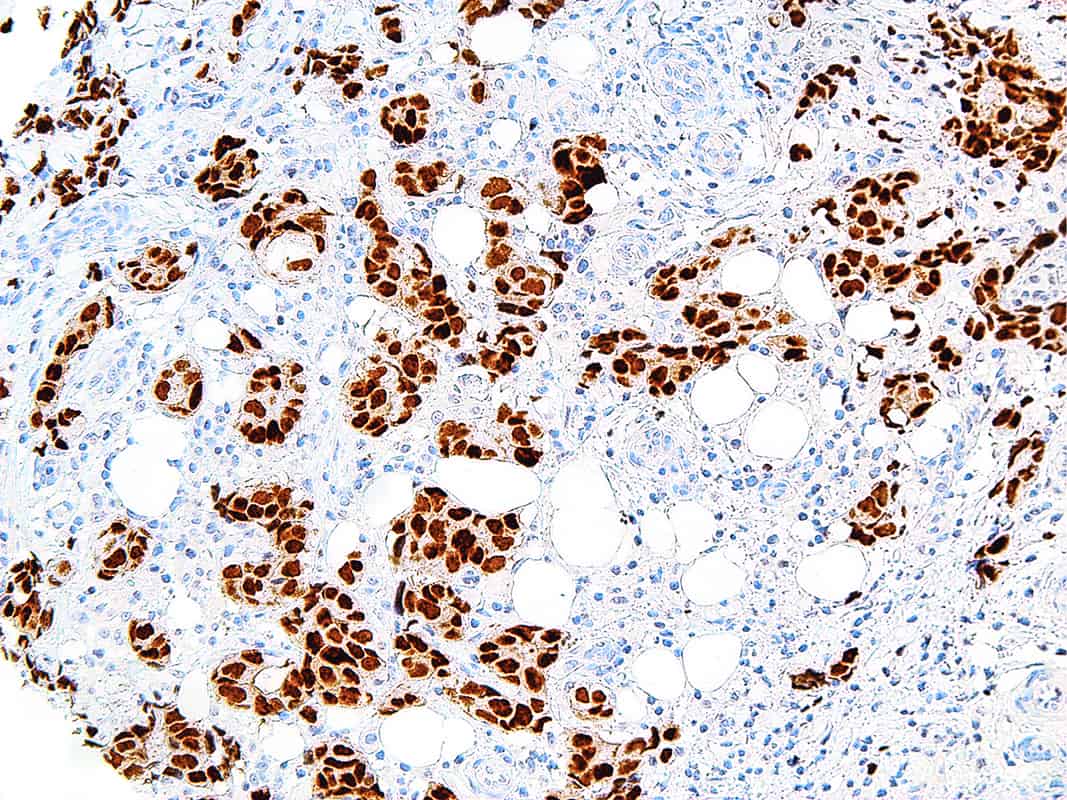

GATA3
GATA3 is a transcription factor important in cell proliferation, development, and differentiation. GATA3 is mostly observed in breast and urothelial carcinomas, and rarely present in other cancers such as endometrial endometrioid adenocarcinoma. Among the breast carcinomas, GATA3 has a lower expression in luminal B subtype breast carcinoma. Studies have found GATA3 expression to be associated with ER (estrogen receptor), PR (progesterone receptor), and Her2 in breast cancer cases. Urothelial carcinomas stain positively for GATA3 in invasive or high grade tumors, therefore Anti-GATA3 is useful for carcinoma diagnosis when breast and bladder are plausible.
Specifications
| Clone | IHC583 |
| Source | Mouse Monoclonal |
| Positive Control | Breast Carcinoma, Urothelial Carcinoma |
| Dilution Range | 1:50-1:200 |
Quantity
1.00
Select Volume
3 slides/package

Reviews
There are no reviews yet.